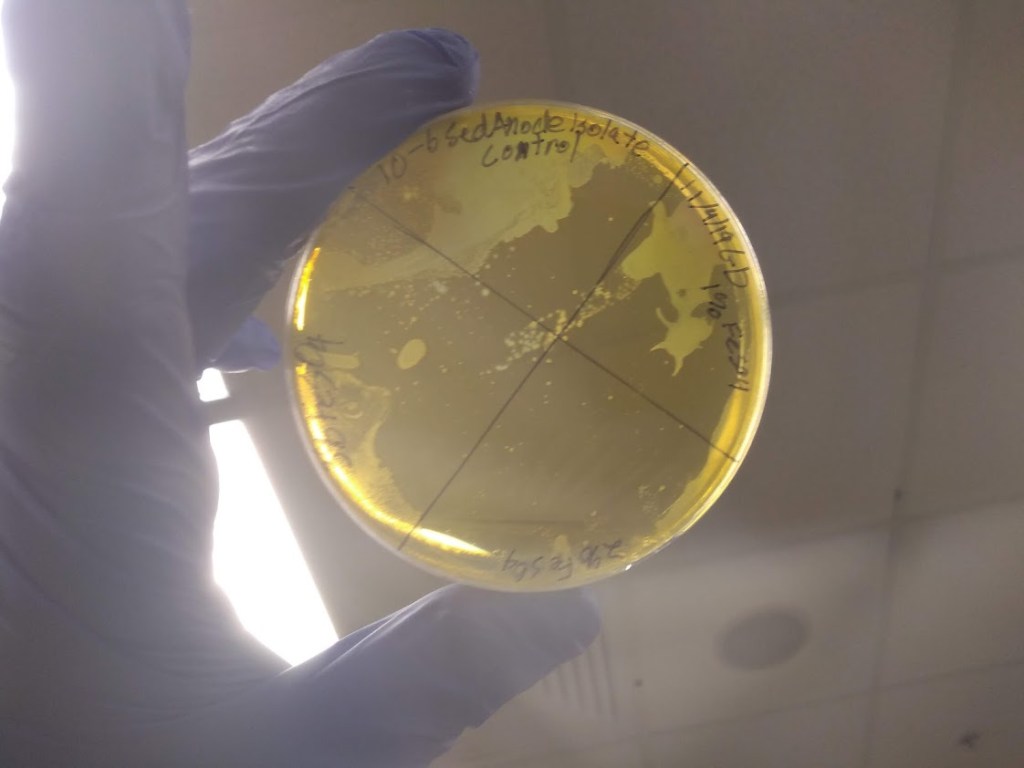
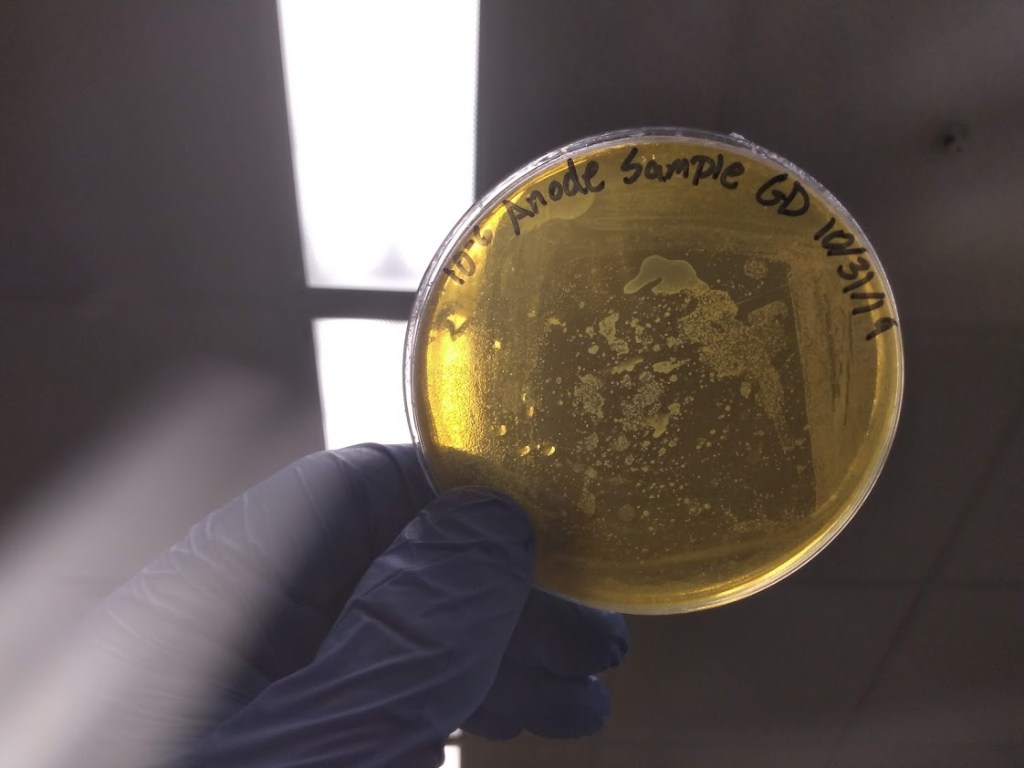
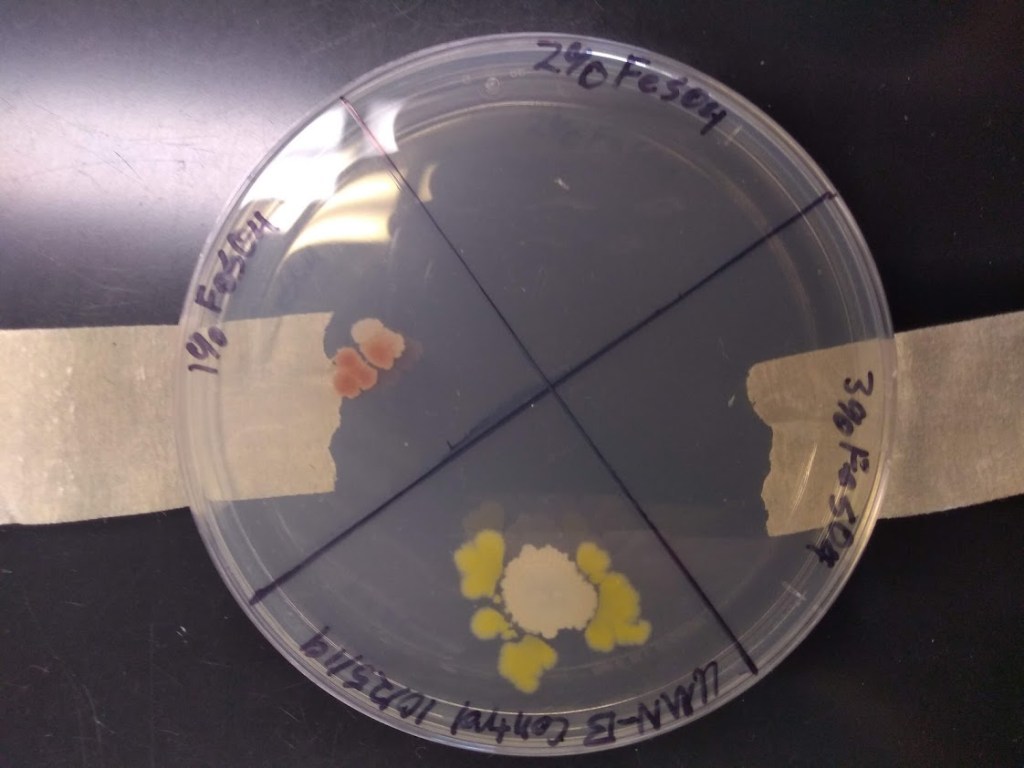
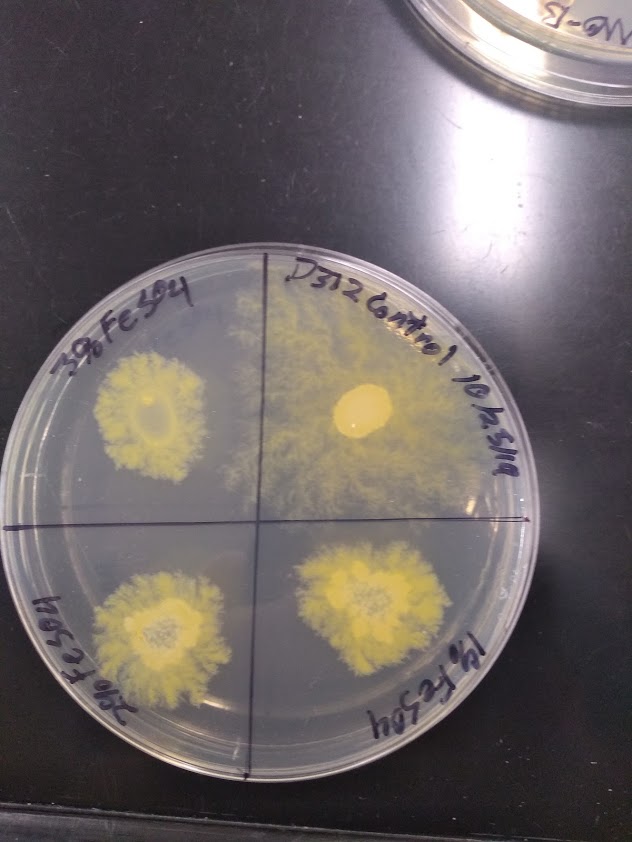

This is a compilation of Research that I’ve been involved in or conducted my self.
Research I’ve Conducted
Microbial Fuel Cells
An Undergraduate Research Project
Microbial Fuel Cells are systems that utilize the metabolism of bacteria to produce electricity and other useful compounds.

Microbial Fuel Cells(MFCs) show a lot of promise as being a green alternative to fossil fuels for power generation thereby helping combat climate. However, the reason that MFCs have garnered great commercial and research interest is their ability to help with wastewater treatment. Microbial Fuel Cells have been studied for quite awhile, since at least the early 20th century. MFCs have always had obstacles to their widespread commercial usage, their biggest obstacle being their low power output. The immense advances seen in material science and genetics could mean that high power MFCs are just around the corner.
Summary
In my last year of my undergraduate degree I embarked on a three semester long research project on Microbial Fuel Cells with an emphasis on finding new species of exoelectrogens, bacteria that have a modified electron transport chain in which the final electron acceptor is not oxygen. I tried three different methodologies for isolating new species of exoelectrogens. My results we’re inconclusive due to time restrictions.
Abstract
Microbial fuel cells are technology that could be another solution to combating climate change while bolstering our ability to produce electricity and revolutionizing our ability to treat wastewater. They’ve been shown to have applications in desalination, bioremediation, and hydrogen production all with the benefit of producing electricity as well. They work on the principle of harnessing a bacteria’s cellular respiration to convert chemical energy into electrical energy, however only certain kinds of bacteria can have their cellular respiration harnessed like this, specifically exoelectrogens. One of the issues that is holding this technology is low amount of exoelectrogens that have been found. In the pursuit of finding more exoelectrogens, this study proposed that new exoelectrogens could be found by screening them for iron tolerance and magnetotaxis. Multiple papers have shown that exoelectrogens can be magnetotatic and have high tolerances to iron. The results of the experiments conducted did not bear this to be true. It is this study’s opinion that the methodology of experiments was flawed and not the general concept that was flawed. More research is needed to fully conclude if this concept is flawed.